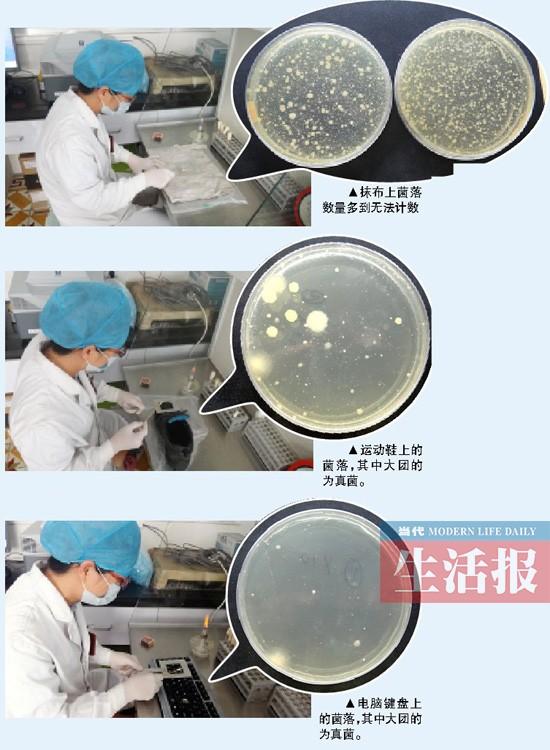
实验显示:抹布细菌最多 鞋上真菌是键盘两倍(图)

细菌图片 实验

血平板上不同细菌菌落形态.#创作灵感 #微生物 #实验室 - 抖音
图片尺寸1920x1808
科学家研究实验显示细菌是如何逃避抗生素对其的迫害
图片尺寸660x495
显微镜,实验室,细菌,水平画幅,微生物学图片素材_id:131423776
图片尺寸612x408
昨天的脓菌药敏实验结果出来啦,最近做实验,前天中午饿的差点自 - 抖
图片尺寸1920x1080![主题:【分享】探访超级细菌实验室[高清组图]](https://i.ecywang.com/upload/1/img0.baidu.com/it/u=1297662650,1226937060&fm=253&fmt=auto&app=138&f=JPEG?w=753&h=500)
主题:【分享】探访超级细菌实验室[高清组图]
图片尺寸900x598
细菌分析实验室显微镜.显微镜下细菌培养的分析.显微镜下细菌的研究.
图片尺寸450x300
细菌的分布——万融实验
图片尺寸640x618
腹泻常见病原菌之沙门菌属.#科普一下 #微观世界 #实验室日 - 抖音
图片尺寸1440x1920
一例萜烯诺卡菌肺炎的实验室诊断
图片尺寸668x670
细菌学图片
图片尺寸452x350
细菌分析实验室显微镜和培养皿与细菌.显微镜下细菌培养的分析.
图片尺寸450x300
显微镜下细菌的研究.实验室科研照片
图片尺寸450x300
研究人员正在实验室里测试细菌.
图片尺寸700x467
新教材:肺炎链球菌转化实验的9个科学问题_细菌
图片尺寸641x427
微生物实验红蓝铅笔图 细菌基本形态和特殊结构 金黄色葡萄球菌
图片尺寸960x1280
实验室的科研.显微镜下细菌的研究照片
图片尺寸450x300
实验显示:抹布细菌最多 鞋上真菌是键盘两倍(图)
图片尺寸550x750
大肠 大肠菌群 大肠菌 微生物实验 生物
图片尺寸3968x2976
细菌科学实验拍摄高清图片
图片尺寸820x656
大肠杆菌革兰氏染色实验
图片尺寸600x374




![主题:【分享】探访超级细菌实验室[高清组图]](https://i.ecywang.com/upload/1/img0.baidu.com/it/u=1297662650,1226937060&fm=253&fmt=auto&app=138&f=JPEG?w=753&h=500)


















![主题:【分享】探访超级细菌实验室[高清组图]](https://img.ycwb.com/news/attachement/jpg/site2/20101030/90fba60187190e35b72d07.jpg)